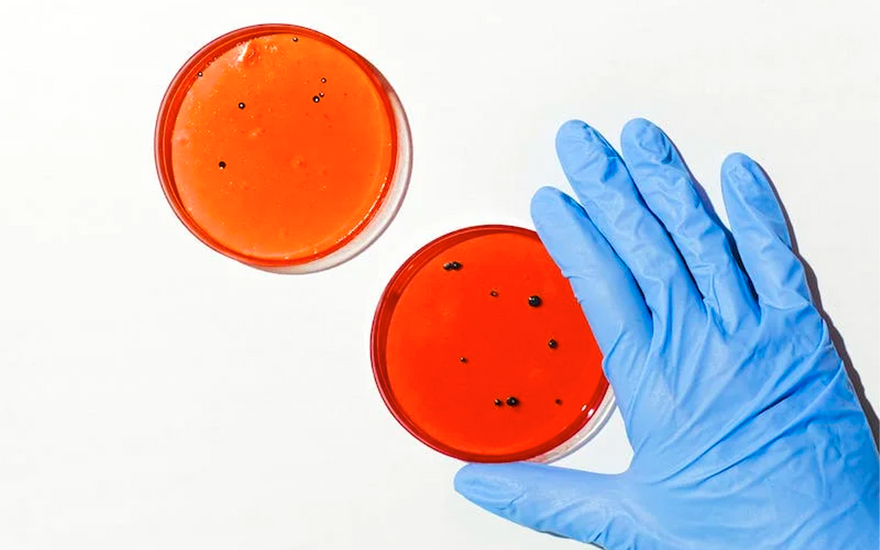
The Mystery of Oral Health: Scientific Analysis of Cell Renewal and Anti-Oral Aging

Blog posts
Add a short description for your blog.
The Mystery of Oral Health: Scientific Analysis of Cell Renewal and Anti-Oral Aging
Oral health is a crucial aspect of our overall well-being. However, many individuals struggle with oral issues such as gum bleeding, oral inflammation, and periodontal diseases. One of the fundamental...

Cellular Maintenance and Deep Oral Cleansing
Our oral cavity, much like our entire body, is composed of thousands of tiny cells. These minuscule entities play a critical role in safeguarding our oral health and functionality. In...

Maintaining Oral Health: The Power of Cells
In our mouths lies a small and invisible world, harboring a profound secret: cells. These tiny life forms constitute the foundation of our oral cavity, providing structural support not only...

Maintaining Oral Health: Nurturing Cells at the Root
In the field of oral health, we often hear keywords like "defense" and "healthy cells." But what exactly do these terms mean, and how do they impact our oral well-being?...

Disrupted Oral Cell Renewal: The Key to Dental Health and Bad Breath
In the realm of oral health, topics like oral inflammation, dental implants, and cold light teeth whitening take center stage. At the core of these concerns lies the disruption of...

A Weapon Against Oral Diseases and Bad Breath
Introduction: Oral health is a crucial component of overall well-being. Disruptions in the renewal of oral cells can lead to oral diseases and bad breath. Today, we will explore Nobaton...

The Scientific Mystery of Caviar Extract in Toothpaste
Oral health has always been a topic of great importance, and now, the scientific community is witnessing a remarkable breakthrough: the use of caviar extract in toothpaste. This innovative technology...

Does whitening toothpaste damage enamel
Many people are troubled by yellow and black teeth caused by dietary habits and improper oral cleaning. There is also concern that whitening toothpaste will damage enamel. So how should...
